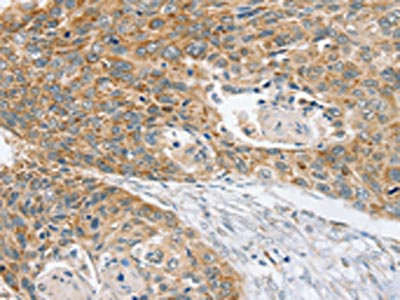

SMC4 Antibody
-
中文名稱:SMC4兔多克隆抗體
-
貨號(hào):CSB-PA189826
-
規(guī)格:¥1100
-
圖片:
-
The image on the left is immunohistochemistry of paraffin-embedded Human liver cancer tissue using CSB-PA189826(SMC4 Antibody) at dilution 1/40, on the right is treated with synthetic peptide. (Original magnification: ×200)
-
The image on the left is immunohistochemistry of paraffin-embedded Human esophagus cancer tissue using CSB-PA189826(SMC4 Antibody) at dilution 1/40, on the right is treated with synthetic peptide. (Original magnification: ×200)
-
-
其他:
產(chǎn)品詳情
-
Uniprot No.:
-
基因名:SMC4
-
別名:CAP C antibody; CAPC antibody; Chromosome associated polypeptide C antibody; Chromosome-associated polypeptide C antibody; hCAP C antibody; hCAP-C antibody; SMC 4 antibody; SMC protein 4 antibody; SMC-4 antibody; SMC4 antibody; SMC4_HUMAN antibody; SMC4L1 antibody; Structural maintenance of chromosomes 4 antibody; Structural maintenance of chromosomes 4 like 1 antibody; Structural maintenance of chromosomes protein 4 antibody; XCAP C homolog antibody; XCAP-C homolog antibody
-
宿主:Rabbit
-
反應(yīng)種屬:Human,Mouse
-
免疫原:Synthetic peptide of Human SMC4
-
免疫原種屬:Homo sapiens (Human)
-
標(biāo)記方式:Non-conjugated
-
抗體亞型:IgG
-
純化方式:Antigen affinity purification
-
濃度:It differs from different batches. Please contact us to confirm it.
-
保存緩沖液:-20°C, pH7.4 PBS, 0.05% NaN3, 40% Glycerol
-
產(chǎn)品提供形式:Liquid
-
應(yīng)用范圍:ELISA,IHC
-
推薦稀釋比:
Application Recommended Dilution ELISA 1:1000-1:2000 IHC 1:25-1:100 -
Protocols:
-
儲(chǔ)存條件:Upon receipt, store at -20°C or -80°C. Avoid repeated freeze.
-
貨期:Basically, we can dispatch the products out in 1-3 working days after receiving your orders. Delivery time maybe differs from different purchasing way or location, please kindly consult your local distributors for specific delivery time.
-
用途:For Research Use Only. Not for use in diagnostic or therapeutic procedures.
相關(guān)產(chǎn)品
靶點(diǎn)詳情
-
功能:Central component of the condensin complex, a complex required for conversion of interphase chromatin into mitotic-like condense chromosomes. The condensin complex probably introduces positive supercoils into relaxed DNA in the presence of type I topoisomerases and converts nicked DNA into positive knotted forms in the presence of type II topoisomerases.
-
基因功能參考文獻(xiàn):
- analysis of functional differences of SMC2 and SMC4 hinge domain between condensins and cohesin in DNA recognition PMID: 26491021
- Results indicate that miR-124-5p may target the tumorigenesis gene, SMC4, which suggests that expression levels of miR-124-5p in plasma and FFPE samples. PMID: 25081869
- Knockdown of SMC-4 expression significantly suppressed the proliferation. PMID: 25422241
- SMC4 expression was significantly associated with tumor size, de-differentiation, advanced stages and vascular invasion of the primary liver cancers. PMID: 22842912
- mutation analysis of hCAP-C & hCAP-E in leukemia-lymphoma cell lines including 8 pyothorax-associated lymphoma (PAL); 3 of 8 PAL cell lines have hCAP-C or hCAP-E heterozygous mutations, indicating condensin mutations are relatively frequent in PAL PMID: 17488335
顯示更多
收起更多
-
亞細(xì)胞定位:Nucleus. Cytoplasm. Chromosome. Note=In interphase cells, the majority of the condensin complex is found in the cytoplasm, while a minority of the complex is associated with chromatin. A subpopulation of the complex however remains associated with chromosome foci in interphase cells. During mitosis, most of the condensin complex is associated with the chromatin. At the onset of prophase, the regulatory subunits of the complex are phosphorylated by CDC2, leading to condensin's association with chromosome arms and to chromosome condensation. Dissociation from chromosomes is observed in late telophase.
-
蛋白家族:SMC family, SMC4 subfamily
-
組織特異性:Widely expressed. Higher expression in testis, colon, thymus.
-
數(shù)據(jù)庫鏈接:
Most popular with customers
-
-
YWHAB Recombinant Monoclonal Antibody
Applications: ELISA, WB, IHC, IF, FC
Species Reactivity: Human, Mouse, Rat
-
Phospho-YAP1 (S127) Recombinant Monoclonal Antibody
Applications: ELISA, WB, IHC
Species Reactivity: Human
-
-
-
-
-